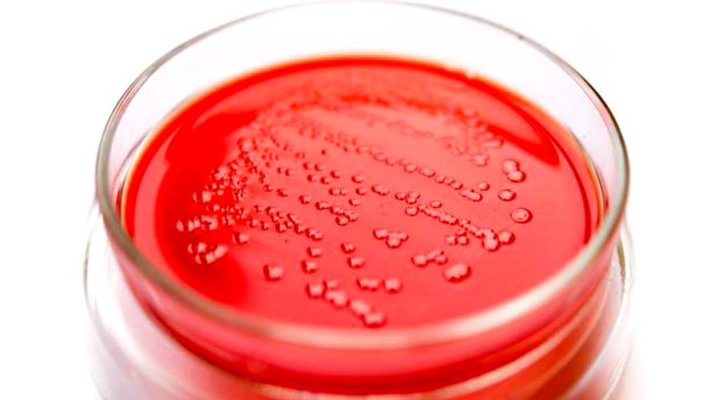
Crean el primer ser vivo con un genoma completamente manipulado

Investigadores de la Universidad de Cambridge (Reino Unido) han creado un microorganismo con todo su ADN alterado radicalmente
Por Gonzalo López Sánchez
Científicos de la Universidad de Cambridge (Reino Unido) han creado el primer organismo que tiene un genoma (el conjunto de todos los genes) completamente modificado por el hombre.
En un artículo publicado en Nature, el equipo del investigador Jason Chin ha relatado cómo ha sido posible crear una cepa artificial de la bacteria Eschericia coli (E. coli), un microbio intestinal muy utilizado en los laboratorios, cuyo material genético ha sido manipulado en su integridad con la finalidad de hacerlo más sencillo.
Los investigadores crearon una gran secuencia de ADN que codifica para aminoácidos, los ladrillos que componen las proteínas, de una forma más simple que la que emplea la naturaleza. Después, fueron capaces de trocear este genoma para ir introduciéndolo poco a poco en el microorganismo.
Finalmente, han logrado que la nueva bacteria E. coli sobreviva con este genoma artificial reducido a la mínima expresión. El organismo, eso sí, crece más lentamente y tiene una forma más alargada.
La búsqueda de vida artificial
Estos resultados han sido posibles gracias a dos años de trabajo y son un importante paso adelante en el campo de la biología sintética, que trabaja en crear vida artificial con la finalidad de diseñar organismos capaces de producir medicamentos, combustibles o degradar productos contaminantes.
Desde hace unas décadas esta es una de las disciplinas científicas más boyantes. Su gran ventaja, al contrario que la biotecnología, es que no se busca reciclar lo que la naturaleza ya ha creado, sino tratar de empezar de cero: en vez de montar un coche a partir de piezas preexistentes, se busca diseñar todo el coche desde el principio.
¿Para qué esforzarse en esto, y no sencillamente seguir ahondando en la biotecnología más tradicional, que también modifica genes? «Una de las razones de crear vida artificial y genomas minimizados es aproximarse al control total del sistema», ha explicado Juli Peretó, vicedirector del Instituto de Biología Integrativa de Sistemas (Universidad de Valencia-CSIC). «El objetivo final es interpretar el funcionamiento de la vida como lo haría un ingeniero con una máquina. Esto es lo que se llama biología sintética».
El camino para lograrlo es extremadamente largo, costoso y complejo, porque requiere comprender con una enorme profundidad la genética de cada ser vivo. La tarea también es difícil porque los genomas son grandes y resulta difícil trabajar con ellos.
Pero si se logra fabricar genomas mínimos que funcionen, se puede crear seres vivos que se comporten como un chasis básico en el que introducir nuevas funciones, bien presentes en otros seres o bien diseñadas de novo.
Reescribir el código genético
En el caso de la investigación de Jason Chin el logro está en que los científicos han manipulado y simplificado todo el genoma, y que además han trabajado con uno muy grande.
Para entender cómo lo han hecho hay que recordar que el ADN contiene las instrucciones con las que las células producen proteínas, máquinas moleculares esenciales para desempeñar muchas funciones básicas.
En realidad, estas instrucciones son transcritas a ARN, una molécula que transfiere el código genético: este es un sistema que depende de cuatro moléculas conocidas como bases nitrogenadas, y que pueden representarse con cuatro letras (A, C, G y U).
Las células leen las secuencias de estas cuatro letras en grupos de tres en tres, que reciben el nombre de codones. La mayoría de estos codones de tres letras «le dicen» a las células que incorporen uno de los 20 aminoácidos de los que están compuestas las proteínas (como la serina o la valina) y no otro. Sin embargo, este código genético está degenerado, lo que quiere decir que resulta reiterativo: hay 64 codones para los 20 aminoácidos.
En esta ocasión, el equipo de Jason Chin trató de acabar con esta redundancia, «liberando» codones para codificar nuevos aminoácios en el futuro.
Para ello emprendió la laboriosa tarea de cambiar la secuencia del ADN de E. coli en 18.000 puntos y así lograr que las proteínas dependieran de 61 codones, y no 64.
Chin ha reconocido en The New York Times que pretende ir más allá en estos trabajos, y que pretende eliminar más de estos codones.
Según Peretó, en efecto, «en este caso lo destacable es que han editado el genoma para reducir la «degeneración» del código genético, es decir, eliminar algunos codones sinónimos y «liberarlos» para que puedan servir para codificar otros aminoácidos».
Sin embargo, ha destacado que «el concepto no es nuevo porque se está aplicando al genoma artificial de levadura, que se estima que se publicará el año que viene».
La vida mínima
El camino de la biología sintética dio un gran salto en 2010, cuando el equipo de investigadores del científico multimillonario Craig Venter logró crear la primera forma de vida con un genoma sintético. Dentro de este ADN los científicos introdujeron varias frases y direcciones de correo electrónico junto a todo lo necesario para la vida de una bacteria. Ya en 2016, Venter sintetizó un genoma con la cantidad indispensable de genes y lo introdujo en una célula preexistente, una pequeña y simple bacteria, con lo que logró crear una forma de vida artificial mínima.
Los expertos consideran que el campo de la biología sintética va a sufrir un gran avance en los próximos años. Sin embargo, por el momento todavía no se han creado genes realmente artificiales, ya que todos los intentos se han limitado a plagiar a la naturaleza o a modificarla en mayor o menor medida.